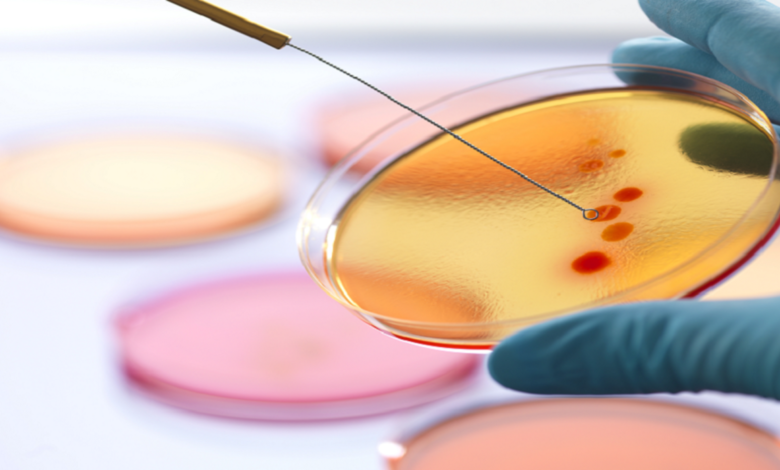

علاج يوصف للكبد يسبب الإصابة ببكتيريا خطيرة
أظهرت دراسة حديثة أن مضادا حيويا يُوصف عادة لمرضى الكبد، قد يزيد من خطر الإصابة ببكتيريا خطيرة، غير قابلة للعلاج.
ووجد فريق دولي من الباحثين في جامعة ملبورن (معهد بيتر دوهرتي للعدوى والمناعة)، أن المضاد الحيوي المعروف باسم “ريفاكسيمين”، والذي يُستخدم غالبا لمرضى الكبد، يمكن أن يؤدي إلى ظهور سلالة مقاومة للمضادات الحيوية تُعرف بـenterococcus faecium المقاومة للفانكومايسين (VRE)، والتي تسبب التهابات حادة غالبا ما تستدعي دخول المستشفى.
وأكدت الدراسة أن استخدام “ريفاكسيمين” يساهم في مقاومة “دابتوميسين”، أحد آخر المضادات الحيوية الفعالة ضد عدوى VRE.
وتسلط الدراسة الضوء على أهمية فهم الآثار السلبية لاستخدام المضادات الحيوية، ما يعزز ضرورة الاستخدام المسؤول لهذه الأدوية في المجال الطبي.
واستندت الدراسة، التي استمرت 8 سنوات، إلى مجالات متعددة، بما في ذلك علم الأحياء الدقيقة وعلم المعلومات الحيوية. وباستخدام تقنيات دراسة الجينوم، تمكن الباحثون من تحديد التغيرات في الحمض النووي للبكتيريا المقاومة لـ”دابتوميسين”، والتي لم تكن موجودة في السلالات الحساسة.
وقد أظهرت التجارب المختبرية والدراسات السريرية أن استخدام “ريفاكسيمين” يؤدي إلى هذه التغيرات وظهور سلالات مقاومة.



